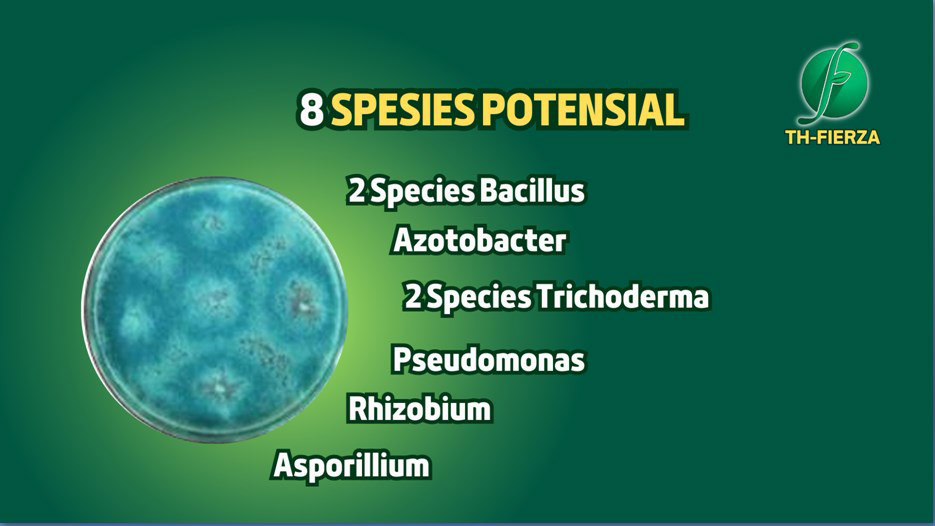

TH-FIERZA pupuk organik bio hayati serbuk powder yang berasal dari bahan-bahan mineral alami hasil olahan teknologi nano yang berbentuk serbuk atau powder, sebagai penghancur, pelarut, pengikat unsur hara (katalis), dan menetralisir residu kimia, sangat direkomendasikan untuk perkebunan sawit sangat bagus untuk meningkatkan hasil dan kuwalitas panen buah sawit
KANDUNGAN PUPUK SAWIT BIO HAYATI TH-FIERZA:

IJIN EDAR KEMENTAN & SERTIFIKAT SUCOFINDO


YANG TIDAK DIMILIKI OLEH PUPUK LAIN
Pupuk bio hayati TH-FIERZA selain menyuburkan & menstabilkan PH tanah, Pupuk TH-FIERZA mengandung organisme yang mampu mengobati, mengatasi bakteri & jamur yang menyerang pada akar dan batang tanaman seperti akar gada, busuk batang/layu fusarium, serta melipat gandakan, melarutkan, meningkatkan serapan unsur hara, tanaman sehat terlindungi dari penyakit dan terpenuhi unsur hara makro dan mikro.
PUPUK SAWIT BIO HAYATI TH-FIERZA MENGANDUNG MICRO ORGANISME SANGAT LENGKAP
Mycoriza, Rhizobium, Acotobacter, Azospirilium
MIKROBA PEMACU PERTUMBUHAN & PERLINDUNGAN TANAMAN
Bacillus, Trichoderma, P.Flourescens, P. Putida, Penecelium, Rhizobium, Azporilum, Azotobakter


Pupuk TH-FIERZA mengandung nutrisi lengkap makro dan mikro tersedia dalam bentuk nano/ion langsung bisa diserap tanaman tanpa melalui proses fotosintesis & mengandung mikro organisme yang mampu menangkap, melipatgandakan unsur hara sehingga terjadi penghematan pupuk

Pupuk TH-FIERZA dikemas berupa sacet sehingga memudahkan dalam pengangkutan kelahan, sehingga akan membantu petani dalam penghematan biaya angkut kelahan

TH-FIERZA mudah untuk diaplikasikan dikemas dalam bentuk sacet mudah dibawa kemanapun, cukup buat lubang pupuk dan ditimbun sangat simple dan irit biaya pemupukan

Pupuk organik TH-FIERZA mengandung unsur hara makro dan mikro lengkap yang siap saji bagi tanaman sehingga memenui nutrisi tanaman dalam setiap fasenya baik vegetatif dan generatif sehingga meningkatkan hasil panen

TH-FIERZA mengandung nutrisi unsur hara makro & mikro lengkap yang dibutuhkan tanaman sehinga bagus untuk melebatkan buah sawit, kwalitas dan kwantitas panen akan meningkat

Pupuk TH-FIERZA Sangat aman dan ramah lingkungan yang tidak membahayakan kesehatan manusia dan hewan ternak karena kandugannya 100% alami
Petunjuk Pengaplikasian Pupuk TH-FIERZA Pada Tanaman Kelapa Sawit
APLIKASI
KETERANGAN

KETERANGAN

Cocok untuk lahan sempit 1500 m2 atau 10 pohon kelapa sawit
1 Boks TH-FIERZA isi 10 Pouch @100gr

Paket isi 14 Boks (140 sacet/pouch) untuk lahan pertanian / perkebunan, 140 pohon kelapa sawit (Hemat 700 ribu)
FREE ONGKIR
Promo Terbatas Setiap Pembelian Paket Agen Gratis Ongkos Kirim


SETIAP PEMBELIAN PAKET AGEN GRATIS ONGKOS KIRIM

SUBUR, MAKMUR, SEHAT, SEJAHTERA